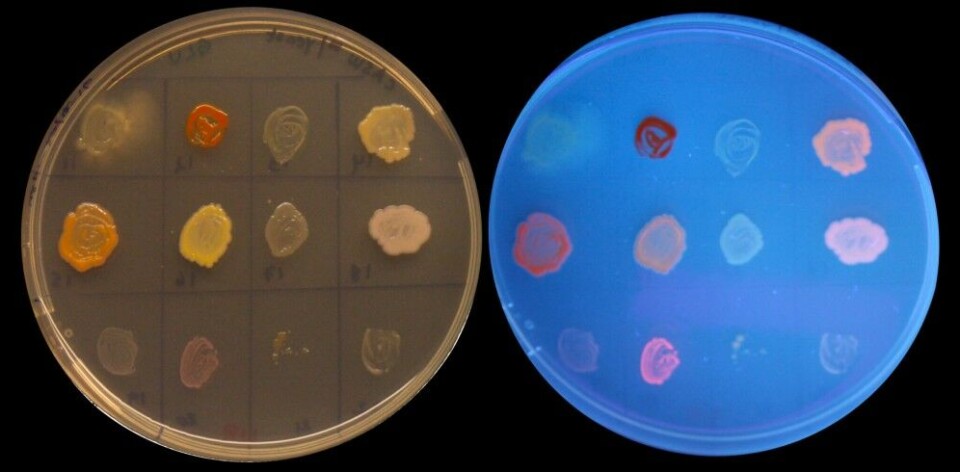

Confronting one of our greatest challenges – plastic waste in nature
The oceans are filling with plastic. The water in some great Asian rivers is no longer visible below the flowing mass of trash. A rare Cuvier’s beaked whale stranded off the coast of Hordaland with its stomach full of plastic. Plastic waste is a formidable problem – with an unexpected possible solution.
By: Vibeke Os // UiT The Arctic University of Norway

Our saviours may be some little rascals with an undeservedly bad reputation – bacteria! It isn’t that they break down plastic waste. Rather, they can produce plastic: eco-friendly, biodegradable plastic.
Plastic as a carbon store
Bacteria are everywhere around us and inside us. It turns out that something akin to plastic serves as an energy reserve for many bacteria. Instead of storing fat for times when food is scarce as people do, bacteria store energy as polyhydroxyalkanoate (PHA), a polymeric compound with properties similar to those of plastic. The PHA polymer is considered the carbon store of bacteria. This biodegradable polymer is stored in large depots inside the bacteria, and scientists around the world are now showing great interest in bacteria that produce “plastic”.
“Lots of bacteria can produce PHA,” explains researcher Hilde Hansen from the Department of Chemistry at UiT The Arctic University of Norway. She is the leader of the MarPlast project, funded through the European Research Area networks initiative (ERANET). She and her research colleague Bjørn Altermark are looking for the best “plastic-producer” among the bacteria in the Arctic marine environment. Their search has led them to fish farms and fish processing plants in Troms County.
Hoping to utilise fishy waste
“In the last few years we’ve been looking for bacteria that are good at producing this plastic and that can be fed easily accessible raw materials,” says Hansen. “We want to utilise excess raw materials that already exist in large quantities that are readily available for large-scale production. We think it’s a very good idea, exploiting leftovers from the fishing and fish farming industries.”
The researchers have visited fishing villages and fish farms, looking for bacteria that survive and thrive on what the fish farm industries leave behind. They have peered into nooks and crannies on boats, at docks, warehouses, fish processing plants, fish farms, and among seaweed and kelp. They take their samples back to the laboratory at the Siva Innovation Centre where scientists test which nutrients the bacteria need in order to grow and produce and store PHA.

Threats can be motivating
The idea of creating biodegradable plastic is not new. Scientists have known since the 1950s that bacteria produce tiny balls of some kind of plastic. The first attempts to exploit these polymers were made in the 1970s but proved too costly to use on an industrial scale.
“And it’s still an expensive process,” Altermark points out.
He explains that this type of research has been on hold for many years, but that the worldwide threat now posed by plastic pollution is increasing the amount of research funding available, and prompting the industry to renewed efforts to produce biodegradable plastics.
PHA molecules are built up in a way that allows microorganisms to chew them to pieces. There are several hundred varieties of PHA. One thing they all have in common is that they consist of the number of repeating building blocks which are linked together in long chains.
Different bacteria produce different PHAs: they use different building blocks and the composition of the PHA is controlled by an enzyme inside the bacteria, which is called polymerase.
In addition to searching for the perfect bacterium, Hansen and Altermark also study various polymerases, since the enzyme is the motor for plastic production inside the bacteria. The researchers want to design an enzyme that is more efficient than the others, a super-enzyme created to produce plastics with unique properties.
“If we learn more about the enzyme, maybe we can create plastics with exactly the properties we want,” says Altermark with a smile. “Then we can choose to make it brittle, rigid, strong or elastic. Just as an example, some surgical suture threads used at hospitals today are made of elastic plastic that decomposes on its own.”
Packaging, straws and plastic bottles
Plastic produced by bacteria could be used for packaging and shopping bags, and could also be mixed with other components to modify the products’ properties and the time they take to decompose. According to the researchers, these new biodegradable plastics can take anywhere from months to years to break down, but they also emphasise that the plastic doesn’t disintegrate by itself. It needs to be introduced into an environment where there are microorganisms that can break it down.
“It is just like paper towels in your kitchen. They will last for years unless you put them in a compost heap. There, they will decompose fairly quickly.”
Long chains
PHA molecules are built up in a way that allows microorganisms to chew them to pieces. There are several hundred varieties of PHA. One thing they all have in common is that they consist of a number of repeating building blocks which are linked together in long chains.
Different bacteria produce different PHAs: they use different building blocks and the composition of the PHA is controlled by an enzyme inside the bacteria, which is called polymerase. In addition to searching for the perfect bacterium, Hansen and Altermark also study various polymerases since the enzyme is the motor for plastic production inside the bacteria. The researchers want to design an enzyme that is more efficient than the others, a super-enzyme created to produce plastics with unique properties.
“If we learn more about the enzyme, maybe we can create plastics with exactly the properties we want,” says Altermark with a smile. “Then we can decide if it should be brittle, rigid, strong or elastic. Just as an example, some surgical suture threads used at hospitals today are made of elastic plastic that decomposes on its own.”
Tested more than 300 bacteria
The two researchers can dream, but a lot of hard work remains to be done. So far, they have tested about 300 bacteria together with project partners in Bucharest and Umeå. Each bacterial strain is cultured in bottles or Petri dishes and examined using microscopy, spectroscopy and chromatography.
They have found 15-20 promising strains of bacteria so far, including halophilic (salt-loving) bacteria of the Halomonadaceae family. These bacteria thrive well in environments with a lot of salt.
Hansen says the challenge is to find the best conditions for PHA production. What makes a bacterium start storing carbon? We know that the relationship between carbon and nitrogen is important, so we want to find conditions that allow the bacteria to thrive and grow as much as possible. We need to look at such things as nutrition, salt concentrations and temperatures. She sums it up this way: “Under certain conditions, 80-90% of the cytoplasm can be PHA. That’s where we want to be.”
This story was originally published by the Fram Forum